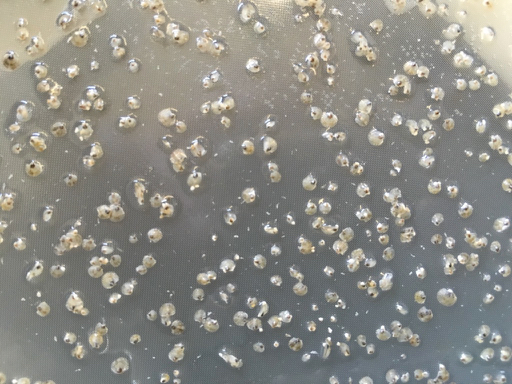

Aquaculture and the Oyster
Raising Oysters
HatcheryIn general, this is a facility where eggs are hatched under artificial conditions, often to optimize production of delicate early life stages. At ABC, the eggs we hatch are oyster eggs, and fertilized eggs develop into oyster larvae. The hatchery is also capable of housing and feeding oyster parents (broodstock) and young oyster seed. The building is equipped with water pumps, filters, and holding tanks to draw and store clean river water, heaters and chillers to control the water temperature, and plumbing to deliver the water to oyster larvae tanks. The hatchery is also equipped with a facility to grow microalgae—food for oysters. |
![]() |
BroodstockThis is an animal that is kept for breeding purposes. At ABC, the best performing oysters or experimental variants are retained by the program and used as parents for future generations. |
![]() |
LarvaeThis is the initial life stage of the oyster. About 90% of oceanic species have a free-swimming larval stage at the beginning of their life cycle. Larval organisms are very small, and some, like oysters, are even microscopic. Oyster embryos will develop into trochophore larvae several hours after eggs are fertilized, and then ‘D-stage’ larvae with thin shells will develop within a day or two. After about two weeks, larvae will more than quadruple in size and develop into pediveliger larvae. As pediveliger larvae, oysters develop a foot-like structure, used to search the seabed for hard substrate for settlement. Once the larvae find a suitable attachment site, they settle, cement to the site, and metamorphose into seed oysters. |
![]() |
SeedThe post-metamorphosis form of the oyster. In this form oysters are sessile (not capable of locomotion) and feed by filtering the passing seawater, ingesting phytoplankton that passes over their gills. Seed oysters usually start out around half a millimeter in size and quickly grow to several millimeters in just weeks. |
![]() |
SpatThe terms “spat” and “seed” are sometimes used interchangeably, however, spat tends to refer to post-metamorphosis oysters that attach to larger, empty oyster shells and are used to plant new oyster beds or reefs in creeks and rivers. Seed tends to refer to loose, single oysters, which are often grown to market size on farms, maintained and sold as individuals. |
![]() |
NurseryA few weeks after oysters metamorphose to their second life stage, the seed stage, they are hearty (and hungry) enough to necessitate transfer from the hatchery to an outside nursery. The nursery consists of several large water troughs. Unfiltered water is pumped from the river into one end of each trough. Fastened within each trough are several upwellers containing the oyster seed. An upweller is a cylinder with a mesh bottom and a drain spout at the top. This design allows water to flow up through the bottom of the cylinder and out the top to an effluent drain attached to the rear of the trough, delivering plenty of water and food to growing seed along the way. |
![]() |
Grow-Out Methods
Oyster Bag
Oysters are placed into rectangular mesh bags for farm grow-out. The plastic mesh is durable, yet lightweight, and comes in various sizes. A smaller mesh size contains juvenile oysters and helps prevent predators (like blue crab) from getting into the bags. Larger mesh size allows for better circulation and food availability for less vulnerable adult oysters.
Cages
Cages are lightweight containers made of thick, coated wire mesh. Cages come in many styles. At ABC, each cage has anywhere from three to six open-ended slots, and each slot can hold one bag of oysters. We call these “bag cages.” Oyster bags are secured in each slot with thick rubber bands or using a wire door. Cages are oriented horizontally, with legs that prevent the structure from sinking into soft bottom. Cages work well when oysters are grown subtidally (always under water), though can be used intertidally if secured to the bottom using an anchor.
Rack-and-Bag
A more permanent gear type are racks. Racks are made of thick, durable, steel rebar and have legs that are pushed into the substrate to secure the rack in place. Once set in place, racks are roughly 12 inches off the bottom. Oyster bags are then strapped onto the top of the racks using thick rubber bands with an S-hook affixed to each end. The rack-and-bag system works well when oysters are grown intertidally (bags are exposed to air at low tide) and can withstand moderate wave action.
Longline
This method of growing oysters involves more substantial equipment. Large, paired pilings are driven deep into the seafloor forming an aisle. The pilings are connected by cables which can be suspended at two or three different heights. Between the sets of cables, hanging baskets are suspended. This allows the grower to choose what height in the water column the oysters are grown, or raise them out of the water for cleaning. The grower can also decide to orient the baskets so that they swing with wave action (“inline”) or are fixed perpendicular to the wave action (“crossline”).
Market Products
Half-shell
The most lucrative part of the oyster market, half-shell refers to oysters that are shipped live, to be shucked (opened) and served to customers, typically in restaurants, often served in half of their shell. These oysters are typically the largest and most proportional, attractive oysters, with desirable flavors or brininess.
Shucked
The shucked market refers to oysters that are opened in a shucking house, refrigerated, and packaged, often in plastic tubs or cans, and shipped to grocery stores and restaurants around the world.